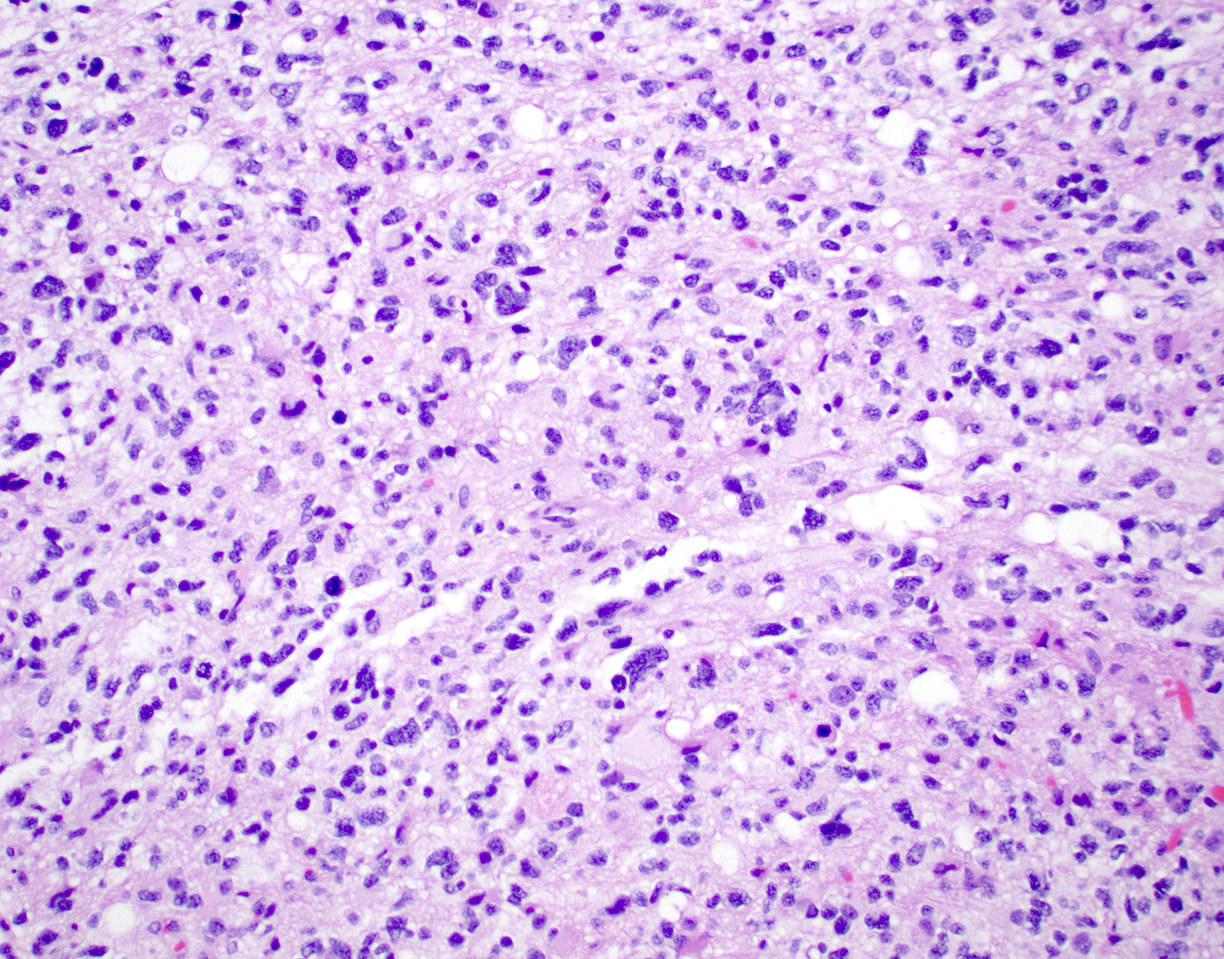

Table of Contents
Definition / general | Essential features | Terminology | ICD coding | Epidemiology | Sites | Pathophysiology | Etiology | Clinical features | Diagnosis | Radiology description | Radiology images | Prognostic factors | Case reports | Treatment | Gross description | Gross images | Frozen section description | Intraoperative frozen / smear cytology images | Microscopic (histologic) description | Microscopic (histologic) images | Cytology description | Positive stains | Negative stains | Molecular / cytogenetics description | Sample pathology report | Differential diagnosis | Additional references | Practice question #1 | Practice answer #1 | Practice question #2 | Practice answer #2 | Practice question #3 | Practice answer #3Cite this page: DeWitt J. Astrocytoma, IDH mutant. PathologyOutlines.com website. https://www.pathologyoutlines.com/topic/CNStumorgliomasastrocytomasIDHmutant.html. Accessed August 10th, 2025.
Definition / general
- IDH1 / IDH2 mutated, diffusely infiltrating glioma, most often with concurrent TP53 or ATRX mutations and without 1p / 19q codeletion
- Can be graded CNS WHO grade 2, 3 or 4
Essential features
- IDH1 codon 132 or IDH2 codon 172 mutated, diffusely infiltrating glioma without 1p / 19q codeletion and usually with TP53 or ATRX mutations
- In the absence of 1p / 19q codeletion, a component that morphologically resembles oligodendroglioma is compatible with this diagnosis
- Can be designated CNS WHO grade 2, 3 or 4 depending on presence of mitotic activity, nuclear atypia, pleomorphism, necrosis, microvascular proliferation or CDKN2A / CDKN2B homozygous deletion
- Significant proliferative activity is consistent with a CNS WHO grade 3 diagnosis
- Presence of either necrosis, microvascular proliferation or CDKN2A / CDKN2B homozygous deletion is consistent with a CNS WHO grade 4 diagnosis
Terminology
- Astrocytoma, IDH mutant, CNS WHO grade 2; previously designated diffuse astrocytoma, IDH mutant
- Astrocytoma, IDH mutant, CNS WHO grade 3; previously designated anaplastic astrocytoma, IDH mutant
- Astrocytoma, IDH mutant, CNS WHO grade 4; previously designated glioblastoma, IDH mutant
- Astrocytoma, IDH mutant, CNS WHO grade 4; historically referred to as secondary glioblastoma
ICD coding
- ICD-11:
- 2A00.0Y & XH6PH6 - other specified gliomas of brain & astrocytoma, NOS
- 2A00.0Y & XH2HK4 - other specified gliomas of brain & diffuse astrocytoma, IDH mutant
Epidemiology
- Age of diagnosis is typically younger than glioblastoma, IDH wild type, with higher grade tumors occurring more often in older patients (third or fourth decade for grade 2 or 3, versus fifth decade for grade 4) (Acta Neuropathol 2015;129:867)
- M > F, within grade 2 and grade 3 tumors (N Engl J Med 2015;372:2481)
- Majority of tumors are sporadic
- A small percentage are associated with familial cancer syndromes, such as neurofibromatosis, tuberous sclerosis and Li-Fraumeni syndrome (Neuro Oncol 2014;16:896)
Sites
- Occurs throughout the CNS but is preferentially located in the cerebral hemispheres, especially the frontal lobes (AJNR Am J Neuroradiol 2012;33:1349)
Pathophysiology
- Cell of origin is unknown, although the commonality of IDH mutation across IDH mutant astrocytoma and oligodendroglioma suggests a common histogenesis in these tumors; similarly, single cell sequencing of IDH mutant gliomas suggests this as well (Acta Neuropathol 2009;118:469, Science 2017;355:eaai8478)
Etiology
- Majority of tumors are sporadic
- A small percentage are associated with familial cancer syndromes, such as Li-Fraumeni syndrome and Ollier disease (Cancer Res 2003;63:6643, Brain Tumor Pathol 2018;35:202)
Clinical features
- Commonly, gradual onset of symptoms
- May present incidentally in work up for headache or following trauma (Lancet Oncol 2017;18:e315)
- Seizures are a common symptom in cerebral hemispheric lesions
- Changes in behavior or personality, especially in frontal lobe tumors
- Uncommonly, site dependent neurological deficits
- Manifestations of increased intracranial pressure
- Often present after a clinical history of a few months of neurologic symptoms
Diagnosis
- MRI with contrast is the preferred imaging modality
- Diagnosis is by biopsy or surgical resection
Radiology description
- CT:
- Expanding, intra-axial, poorly defined mass of low density
- Variable calcification may be seen
- Contrast enhancement and central hypodensity due to necrosis, occur with higher grades
- MRI:
- T1 hypodensity and T2 hyperintensity
- T2 hyperintensity with relative FLAIR sequence hypointensity (T2 FLAIR mismatch) is a relatively suggestive indication of IDH mutant astrocytoma (Clin Cancer Res 2017;23:6078)
- Distortion and enlargement of involved areas, including associated cortical ribbon
- Contrast enhancement is typically present in higher grade tumors (J Neurooncol 2019;141:327)
- Ring-like enhancement around central necrosis typical of grade 4
Radiology images
Prognostic factors
- Within IDH mutant astrocytoma, younger age is correlated with improved prognosis and survival (Acta Neuropathol 2018;136:153)
- Extent of resection and the presence or absence of residual tumor post surgery also correlates with survival (Neuro Oncol 2014;16:81)
- Proliferative activity, including mitotic count and Ki67 index, are not clearly correlated with differences in prognosis within grade 2 and grade 3 astrocytoma, IDH mutant (J Neuropathol Exp Neurol 2019;78:1002, Brain Pathol 2020;30:541, Oncotarget 2016;7:21190)
- Astrocytoma, IDH mutant tumors containing any CNS WHO grade 4 features (necrosis, microvascular proliferation or CDKN2A / CDKN2B homozygous deletion) have a significantly worse prognosis than CNS grade 2 or 3 tumors (Acta Neuropathol 2018;136:153)
- Even within histologic CNS WHO grade 4 tumors, the presence of CDKN2A / CDKN2B homozygous deletion may portend a worse prognosis (Neuropathol Appl Neurobiol 2019;45:108)
Case reports
- 12 year old girl with constitutional mismatch repair deficiency syndrome and concomitant IDH wild type glioblastoma and IDH1 mutant anaplastic astrocytoma (Neuropathol Appl Neurobiol 2018;44:233)
- 28 year old man with widely metastatic IDH1 and TP53 mutant glioblastoma with atypical molecular features (Diagn Pathol 2019;14:16)
- 28 year old woman with symptoms of postpartum depression (J Med Case Rep 2018;12:374)
- 40 year old man with long term daily temozolomide with dose dependent efficacy in MGMT promotor methylation negative, recurrent, high grade astrocytoma (Cancer Chemother Pharmacol 2017;80:1043)
Treatment
- Complete resection as extensively as is safely possible (Neuro Oncol 2015;17:868)
- Chemotherapy (temozolomide) or radiation therapy
Gross description
- Ill defined neoplasm with blurring of gray-white junction and expansion of the infiltrated brain areas
- Variable textures: firm, soft, gelatinous, granular, depending on CNS WHO grade (cellularity, necrosis)
- Variable microcystic change imparting a spongy appearance
- Variable calcification with a gritty sensation
- Typically invades surrounding brain without overt tissue destruction
- Expands native structures and can give a mass-like appearance on cut section
- Areas of granularity or softening may be present
- Soft gray-tan tissue with variable yellow-tan necrotic material
- Often fragmented
- Interface of tumor with brain parenchyma is indistinct
Frozen section description
- Smear done at the time of frozen section will show astrocytic appearing tumor cells with oblong irregular nuclei with varying degrees of atypia and glial processes
- High grade nuclear features and mitotic activity may be observed on frozen section but necrosis or microvascular proliferation (features of glioblastoma) should not be present
- Cellular morphology can be highly variable
- Often predominantly tumor cells with oval hyperchromatic nuclei in a fibrillary background
- Variably present, larger cells and pleomorphism
- Variable quantity of cells with eccentric nuclei and glassy eosinophilic cytoplasm (gemistocytes)
- Some show predominantly small cells with little pleomorphism and scant cytoplasm
- Sections are hypercellular showing infiltrating neoplastic cells with edema
- Variably present mitotic figures, necrosis and microvascular proliferation
- Vascular thromboses and myxoid background may be present
- Smear most commonly shows predominantly smaller cells with fine fibrillar processes, elongated nuclei, nuclear atypia and may show mitotic figures
Intraoperative frozen / smear cytology images
Microscopic (histologic) description
- Diffusely infiltrating tumor cells with oval to elongated astrocytic nuclei and varying appearance of tumor cytoplasm and fibrillar glial processes (Acta Neuropathol 2015;129:789)
- At the periphery, tumor cells may infiltrate in a diffuse single cell pattern, often with entrapped neurons and axons
- Cellular morphology is variable, even within a single tumor
- Commonly there is a mix of cells with elongated nuclei and fine fibrillar processes, cells with eccentric nuclei and glassy eosinophilic cytoplasm (gemistocytes), larger pleomorphic cells and small cells with scant cytoplasm
- May show oligodendroglioma-like areas
- Myxoid background and microcyst formation may be present
- Variable mitotic activity, cellularity and nuclear atypia depending on CNS WHO grade
- In small biopsy specimens, the presence of 1 mitosis may be sufficient for a CNS WHO grade 3 diagnosis, while the presence of a few mitotic figures in a large resection would not be sufficient for grade 3 designation (Acta Neuropathol 2020;139:603)
- Presence of necrosis or microvascular proliferation would be consistent with a CNS WHO grade 4 designation
Microscopic (histologic) images
Contributed by Eman Abdelzaher, M.D., Ph.D., John DeWitt, M.D., Ph.D. and Meaghan Morris, M.D., Ph.D.
Cytology description
Positive stains
- GFAP (variable)
- Olig2
- IDH1
- Marker of infiltrating gliomas, both astrocytic or oligodendroglial (Curr Neurol Neurosci Rep 2013;13:345)
- Recognizes only the most common mutation (IDH1 R132H, which accounts for about 90% of all glioma associated IDH mutations) (Neuro Oncol 2014;16:1478)
- In the absence of immunohistochemical evidence for IDH mutation, other IDH1 / IDH2 mutations must be diagnosed by mutational analysis (Neuro Oncol 2014;16:1478)
- Rare in children < 14 years (Childs Nerv Syst 2011;27:87)
- p53
- Ki67: increasing proliferation index with increasing grade
- Neurofilament (highlights entrapped axons)
Negative stains
- ATRX
- Loss of nuclear ATRX is typical of diffuse astrocytomas, not oligodendrogliomas or reactive gliosis (Front Oncol 2017;7:236)
- Strong nuclear expression in nonneoplastic vasculature and cells serves as an internal control
- Keratins (although cocktails may show cross reactivity)
- CAM5.2, CD45, CD20, MelanA
Molecular / cytogenetics description
- IDH1 or IDH2 mutation necessary for the diagnosis, with R132H IDH1 variant seen in > 90% of cases (Acta Neuropathol 2009;118:469)
- Tumors negative for R132H IDH1 immunohistochemistry require IDH1 / IDH2 sequencing to determine IDH status (Neuro Oncol 2017;19:1640)
- p53 mutation and ATRX promoter mutation nearly always present (typically absent in oligodendroglioma, IDH mutant and 1p19q codeleted) (N Engl J Med 2015;372:2481)
- Gain of chromosome 7
- Usually lack TERT promoter mutations
- Presence of CDKN2A / CDKN2B homozygous deletion portends a worse prognosis and is sufficient for a CNS WHO grade 4 designation regardless of histologic features present (Acta Neuropathol 2018;136:153)
Sample pathology report
- Brain, frontal lobe, biopsy:
- Integrated diagnosis: astrocytoma, IDH mutant, CNS WHO grade 4
- Histological diagnosis: astrocytoma with elevated proliferative activity and necrosis
- WHO histological grade: 4
- Molecular information:
- IDH1: mutant (R132H immunohistochemistry)
- ATRX: nuclear expression lost (consistent with mutant)
- p53: many positive cells (immunohistochemistry; consistent with mutant)
Differential diagnosis
- Normal brain:
- Demyelinating disease:
- Pilocytic astrocytoma:
- Circumscribed and contrast enhancing, histologically compact biphasic architecture (alternating piloid and spongy areas)
- IDH1 negative
- Reactive gliosis:
- Evenly distributed hypertrophic astrocytes, IDH1 negative
- Glioblastoma, IDH wild type:
- High grade infiltrative glial neoplasm with astrocytic differentiation, nuclear atypia, pleomorphism, elevated mitotic activity and necrosis or microvascular proliferation
- IDH mutation is not present by immunohistochemistry or sequencing
- Oligodendroglioma, IDH mutant and 1p / 19q codeleted:
- Infiltrating glioma composed of round cells resembling oligodendrocytes, hyperchromatic rounded nuclei, perinuclear halos, fine branching vasculature, scattered calcifications
- Grade 3 tumors may have increased mitotic activity, variable microvascular proliferation and variable necrosis
- IDH1 / IDH2 mutation present by immunohistochemistry or sequencing and whole arm codeletion of chromosomes 1p and 19q must be present by molecular testing
- ATRX alterations and TP53 mutations are typically absent (Acta Neuropathol 2012;124:615, N Engl J Med 2009;360:765)
- Lymphoma:
- Parenchymal lymphomas in the central nervous system are typically diffuse large B cell lymphomas, which lack the fine fibrillar cell processes typical of glial cells
- Diffuse large B cell lymphoma in the central nervous system often shows a perivascular tumor distribution
- Positive for CD45 and CD20 but negative for GFAP and Olig2 by immunohistochemistry
- Metastatic disease:
Additional references
Practice question #1
Which of the following is true about IDH mutant astrocytoma?
- Codeletion of chromosomes 1p and 19q is a characteristic molecular alteration
- IDH mutant astrocytomas have a significantly better prognosis than IDH wild type tumors
- IDH protein expression is detected in astrocytic tumors only
- Malignant progression to higher grades does not occur
- Retained nuclear ATRX is typical of IDH mutant astrocytomas
Practice answer #1
B. IDH mutant astrocytomas have a significantly better prognosis than IDH wild type tumors
Comment Here
Reference: Astrocytoma, IDH mutant
Comment Here
Reference: Astrocytoma, IDH mutant
Practice question #2
Which of the following is true about the entity in the figure above presenting in a 50 year old man?
- If R132H IDH1 immunohistochemistry is negative, no further testing is necessary
- If R132H IDH1 immunohistochemistry is positive, ATRX staining of tumor cells is expected to be lost
- If R132H IDH1 immunohistochemistry is positive, ATRX staining of tumor cells is expected to be retained
- If R132H IDH1 immunohistochemistry is positive, patient survival is similar to glioblastoma, IDH wild type
- If R132H IDH1 immunohistochemistry is positive, p53 staining of tumor cells is expected to be weak and scattered
Practice answer #2
B. If R132H IDH1 immunohistochemistry is positive, ATRX staining of tumor cells is expected to be lost. The image is consistent with an infiltrating astrocytoma with significant pleomorphism and mitotic activity. If R132H IDH1 immunohistochemistry is positive, as stated in answer B, the findings are then consistent with astrocytoma, IDH mutant, CNS WHO grade 3. Astrocytoma, IDH mutant tumors often show concurrent ATRX mutation, indicated by loss of staining in tumor cells with ATRX immunohistochemistry.
Comment Here
Reference: Astrocytoma, IDH mutant
Comment Here
Reference: Astrocytoma, IDH mutant
Practice question #3
You are working up a diffusely infiltrating glial tumor and find tumor cells are positive for R132H IDH1 and have lost ATRX. What histologic or molecular features would be consistent with a diagnosis of astrocytoma, IDH mutant, CNS WHO grade 3?
- CDKN2A / CDKN2B homozygous deletion
- Microvascular proliferation
- Mitoses and pleomorphism in the absence of necrosis, microvascular proliferation or CDKN2A / CDKN2B homozygous deletion
- Necrosis
- Necrosis, microvascular proliferation or CDKN2A / CDKN2B homozygous deletion
Practice answer #3
C. Mitoses and pleomorphism in the absence of necrosis, microvascular proliferation or CDKN2A / CDKN2B homozygous deletion. The presence of mitoses and pleomorphism in the absence of necrosis, microvascular proliferation or CDKN2A / CDKN2B homozygous deletion is consistent with a diagnosis of astrocytoma, IDH mutant, CNS WHO grade 3. The presence of necrosis, microvascular proliferation or CDKN2A / CDKN2B homozygous deletion would be consistent with astrocytoma, IDH mutant, CNS WHO grade 4. An infiltrating astrocytoma with IDH mutation and no significant proliferative activity, pleomorphism, necrosis, microvascular proliferation or CDKN2A / CDKN2B homozygous deletion would be consistent with astrocytoma, IDH mutant, CNS WHO grade 2.
Comment Here
Reference: Astrocytoma, IDH mutant
Comment Here
Reference: Astrocytoma, IDH mutant